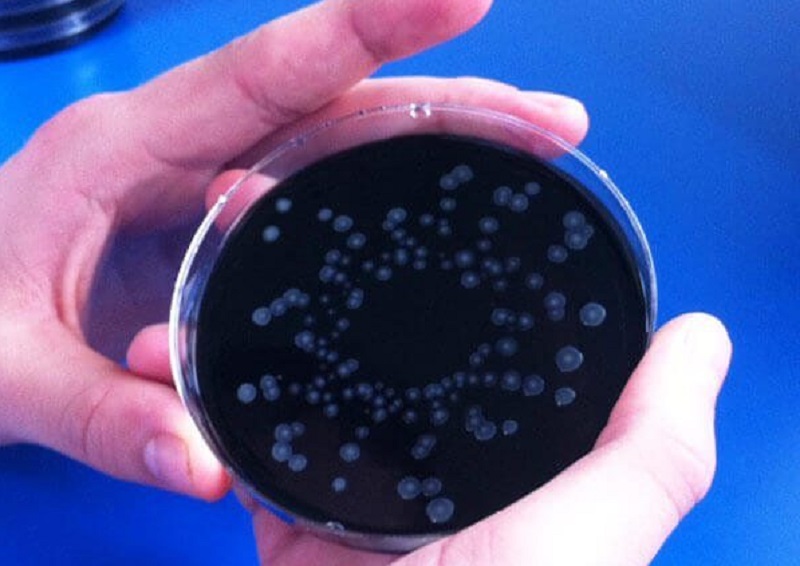
Legionella, termina l’allerta al campo sportivo di Garbagnate

Legionella, terminato il pericolo contagio al centro sportivo di via Montenero a Garbagnate. Il sindaco ora punta alla ristrutturazione dell’impianto.
Legionella, termina l’allerta al campo sportivo di Garbagnate
Dopo l’attenta lettura della nota proveniente dal dipartimento di Igiene e Prevenzione dell’azienda sanitaria locale che ha campionato l’acqua del centro sportivo di via Montenero,il sindaco Davide Barletta ha deciso pochi giorni fa di riaprire i rubinetti della struttura. Terminato dunque il pericolo di contagio. La vicenda che tenne con il fiato sospeso molti sportivi che frequentano il Centro sportivo era nata come un fulmine a ciel sereno, pochi mesi fa. Durante le verifiche periodiche fu segnalata nell’acqua calda e fredda delle docce la presenza di colonie batteriche della Legionella Pneumophila; un temibile batterio che provoca un particolare tipo di polmonite difficile da curare e fatale per i soggetti più deboli.
Il sindaco: “Bonifica efficace, valori conformi”
«Le procedure di bonifica con le modalità previste dalla legge sono state effettuate con successive analisi e rapporti di prova sull’acqua sanitaria e in tutta la struttura del Centro Sportivo – spiega a Settegiorni Barletta –, tutti i certificati delle analisi effettuate attestano l’efficacia della bonifica, con valori totalmente conformi. Ritenuto che la situazione di emergenza igienica sia da considerarsi rientrata per i fruitori delle strutture di via Montenero abbiamo revocato tutte le misure restrittive relative all’utilizzo dell’acqua calda in tutto il Centro».
E ora ristrutturazione del centro sportivo
Dichiarata definitivamente conclusa l’emergenza con il ripristino delle funzioni, il sindaco sta già pensando a come muoversi per una poderosa ristrutturazione del Centro sportivo, oggi molto ammalorato. Le prossime comunicazioni della giunta su questa area riguarderanno novità e sorprese come promesso nel programma elettorale del maggio scorso.